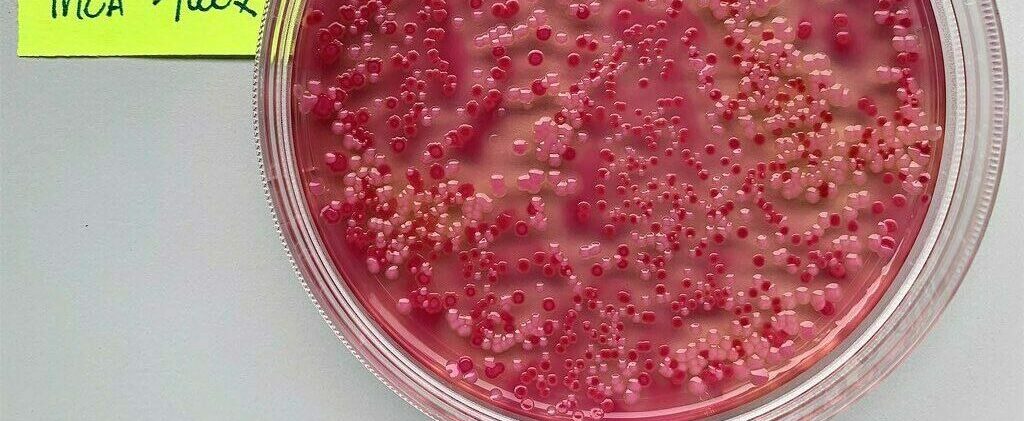

Sign up here to attend the physical event
Sign up here to attend the physical event
Sign up here to attend the live-stream session
Come ask our experts what the future holds for AMR
Antimicrobial resistance (AMR) is on the rise, in India, in Switzerland, everywhere. Addressing this pandemic has become one of the biggest challenges to human and animal health, starting from keeping up with the emerging resistance mechanisms of bacteria, innovation of new antibiotics to AMR stewardship and fully understanding its implications for public health.
To address this challenge, it is crucial to work outside of silos and open channels between academia, innovation, practitioners and stewards of good practice. With this Science Curio session, we bring together expert perspectives from AMR research and public health, from India and Switzerland. The exchanges are sure to inspire the next generation scientists and entrepreneurs to take on this challenge and excel in a collaborative way without borders.
Bio
Prof. Gagandeep Kang is an Indian virologist who is the Professor in the Department of Gastrointestinal Sciences at the Christian Medical College, Vellore, India and served as executive director of the Translational Health Science and Technology Institute, Faridabad, an autonomous institute of the Department of Biotechnology, Ministry of Science and Technology, Government of India from August 2016 to July 2020. She is a leading researcher with a major research focus on viral infections in children, and the testing of rotaviral vaccines.
Bio
Dr. Taslimarif Saiyed is the CEO and Director of C‐CAMP from 2009, and also heads the Discovery to Innovation Accelerator program at C‐CAMP. He is actively involved in promoting innovation in lifesciences / healthcare by supporting translation of discoveries to application, entrepreneurship and technology development. Dr. Saiyed is an Adjunct Faculty at Indian Institute of Technology (IIT) Madras and Amrita Institute ‐ School of Biotechnology since 2015.
Bio
Prof. Endimiani is an internationally recognised expert in characterisation of multi drug-resistant (MDR) Gram-negative bacteria, kinetic analysis of β-lactamases, evaluation of new antimicrobials, implementation of novel diagnostic techniques, epidemiological surveys, and clinical studies linking the antibiotic resistance with the outcome of human infections. He is currently an Associated Professor at the University of Bern – Institute for Infectious Diseases, and is supported by the Swiss National Science Foundation (SNF grant 192514) and the NRP-79, “National Research Programme: Advancing 3R – Animals, Research and Society” (SNF grant 206400).
Bio
Dr Nishad Matange has recently been awarded the DBT/Wellcome Intermediate Fellowship and the Ben Barres Spotlight Award for his research on antimicrobial resistance. A PhD from the Indian Institute of Science, he has now set up an independent research group at IISER Pune. Initially as a DST-INSPIRE Faculty Fellow and then as an Assistant Professor in the Dept. of Biology, his research interest is to understand the evolutionary genetics of AMR in Gram negatives.
Breaking the silos in AMR research: Our curated Indo-Swiss expert exchange featuring specialists behind the fight against antimicrobial resistance
Lena Robra, our Head of Academic Engagement explores fresh perspectives on AMR, and its impact on our transforming society.
Read more